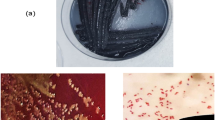

Abstract
Dental caries and periodontal disease are widespread diseases for which microorganism infections have been identified as the main etiology. Silver nanoparticles (Ag Nps) were considered as potential control oral bacteria infection agent due to its excellent antimicrobial activity and non acute toxic effects on human cells. In this work, stable Ag Nps with different sizes (~5, 15 and 55 nm mean values) were synthesized by using a simple reduction method or hydrothermal method. The Nps were characterized by powder X-ray diffraction, transmission electron microscopy and UV–vis absorption spectroscopy. The antibacterial activities were evaluated by colony counting assay and growth inhibition curve method, and corresponding minimum inhibitory concentration (MIC) against five anaerobic oral pathogenic bacteria and aerobic bacteria E. coli were determined. The results showed that Ag Nps had apparent antibacterial effects against the anaerobic oral pathogenic bacteria and aerobic bacteria. The MIC values of 5-nm Ag against anaerobic oral pathogenic bacteria A. actinomycetemcomitans, F. nuceatum, S. mitis, S. mutans and S. sanguis were 25, 25, 25, 50 and 50 μg/mL, respectively. The aerobic bacteria were more susceptible to Ag NPs than the anaerobic oral pathogenic bacteria. In the mean time, Ag NPs displayed an obvious size-dependent antibacterial activity against the anaerobic bacteria. The 5-nm Ag presents the highest antibacterial activity. The results of this work indicated a potential application of Ag Nps in the inhibition of oral microorganism infections.
Similar content being viewed by others
Explore related subjects
Discover the latest articles, news and stories from top researchers in related subjects.Avoid common mistakes on your manuscript.
1 Introduction
Dental caries and periodontal disease are widespread diseases, both of which are highly prevalent in industrialized societies, and are on the increase in developing countries [1, 2]. In a national survey in China in 2008, 66 % of 5-year-old children examined had caries in their primary dentition, while this figure rose to 88.1 % in the permanent dentition of 35–44-year-old. Periodontal diseases are more common in adult, for example, 77.3 % of 35–44-year-old had bleeding gums, 97.3 % had calculus and 40.9 % had periodontal pockets [3]. Dental caries and periodontal disease result from a complex interaction of environmental triggers, the resident microorganisms and the host. If the composition of individual’s resident oral microorganisms is out of balance, dental disease can occur [4–6]. Anaerobic gram-positive streptococcus Streptococcus mutans (S. mutans), Streptococcus sanguis (S. sanguis) and Streptococcus mitis (S. mitis) are commonly recovered from carious dentine, infected pulp chambers, advanced forms of periodontal disease and dental abscesses [4, 7, 8]. Anaerobic gram-negative rods Actinobacillus actinomycetemcomitans (A. actinomycetemcomitans) and Fusobacterium nuceatum (F. nuceatum) are pathogens of aggressive forms of periodontal disease in adolescents and periodontal pockets [4, 9, 10]. In order to prevent and control dental caries and periodontal disease, it must be applied materials to kill or inactivate the causative bacteria. The use of some antimicrobials have resulted in the diminution of the prevalence of dental diseases, but it has been reported that antibiotics and chemical bactericides often disturb the bacterial flora of the oral cavity and digestive tract [11, 12]. More importantly, more and more pathogenic bacteria have developed resistance against various antibiotics [13, 14]. There is a need in the use of an agent who does not generate resistance and presents a good antibacterial property.
Silver nanoparticles (Ag Nps), exhibiting very strong antibacterial activity against both gram-positive and gram-negative bacteria including multriresistant strains [15–19], can be considered as potential anti-oral bacteria agent. The antibacterial activity of Ag Nps against Escherichia coli (E. coli) and Staphylococcus aureus was reported and found to be size dependent [20–24]. However, few works have been focused on the investigation of the antibacterial activity of Ag Nps against oral bacterial. Hernández-sierra et al. determined the antibacterial activity of silver, zinc oxide, and gold Nps against S. mutans and found that Ag Nps showed the best antimicrobial effect [25]. Espinosa-Cristobal et al. [12] compared the bacteriostatic effects of three sizes of Ag Nps (8.4, 16.1 and 98 nm) against S. mutans and found the antibacterial property depend on the size of the particles, and 8.4 nm Ag NPs had the best antibacterial activity. Slenters et al. [26] reported that dental implant and restorative materials with a silver polymer compound had shown effective antimicrobial properties against S. sanguis. Sadeghi et al. [27] found that the antimicrobial activity of Ag Nps is stronger than that of chlorhexidine mouthwash against S. sanguis and Actinomyces viscosus.
In this study, stable Ag Nps with different size were prepared and characterized. The antibacterial activities of as-synthesis Nps were determined against five anaerobic oral pathogenic bacteria, gram-positive S. mutans, S. sanguis, S. mitis and gram-negative A. actinomycetemcomitans, F. nuceatum, and aerobic bacteria E. coli. To the best of our knowledge, the antibacterial activity of Ag Nps against the oral pathogenic bacteria S. mitis, A. actinomycetemcomitans and F. nuceatum have not been reported.
2 Materials and methods
2.1 Materials and bacterial strains
Aerobic bacteria E. coli CCTCC AB 90054 was supplied by college of life science, Huazhong Normal University. The five anaerobic oral bacterial strains, gram-positive streptococcus S. mutans ATCC 35668, S. sanguis ATCC 10556, S. mitis ATCC 15914 and gram-negative rods A. actinomycetemcomitans ATCC 29523, F. nuceatum ATCC 25586 were obtained from Faculty of Dentistry, The University of Hong Kong.
The components of the Luria–Bertani (LB) medium were used in growing and maintaining E. coli and the component of brain–heart-broth infusion (BHI, Oxoid) and columbia blood agar (Oxoid) were used in growing and maintaining the oral bacteria. Analytical grade reagents from Sigma-Aldrich and Aladdin were used for the synthesis of Ag Nps. Deionized water was used for the preparation of solutions.
2.2 Synthesis
2.2.1 Sample 1
0.5 mL AgNO3 (0.2 M) and 0.25 g poly(N-vinyl-2-pyrrolidone) (PVP, MW ≈ 55000) were added to a round-bottom flask which contained 5 mL of deionized water. The mixture was stirred for 30 min, then NaBH4 (0.1 M) solution was added slowly until Ag+ were reduced fully under vigorous stirring.
2.2.2 Sample 2
0.5 mL AgNO3 (0.05 M) and 0.25 g PVP were added to 25 mL of 2-[4-(2-Hydroxyethyl)-1-piperazinyl]ethanesulfonic acid (HEPES) buffer (100 mM, pH 7.4). Upon stirring for 30 min, NaBH4 (0.1 M) was added into until Ag+ were reduced fully.
2.2.3 Sample 3
0.444 g of PVP was added in 40 mL of polyethylene glycol (PEG) 600 under stirring at 80 °C. After the solution became transparent, 1 mL AgNO3 (0.5 M) was rapidly injected into. The mixture was heated at 200 °C for 24 h and cooled at room temperature.
2.3 Characterization
The as-prepared samples were characterized by powder X-ray diffraction (XRD), transmission electron microscopy (TEM) and UV–vis spectroscopy. XRD was carried out on Bruker axs D8 Discover (Cu Ka = 1.5406 Å). The scanning rate is 1° min−1 in the 2θ range from 20° to 80°. TEM analysis was performed on Philips Tecnai G2 20 electron microscope, using an accelerating voltage of 200 kV. The samples for TEM observations were prepared by dispersing some of the solid products into ethanol and then sonicated for about 30 s. A few drops of the suspension were deposited on the copper grid, which was then put into the desiccator. UV–Vis spectroscopy was recorded on Shimadzu UV-2550.
2.4 Antibacterial test
The antibacterial activity of the as-synthesized samples against E. coli and the oral pathogens were performed by two methods: colony counting assay and growth inhibition curve method. The colony counting assay was performed by culturing 10 μL of 103 CFU/mL of E. coli or F. nuceatum on LB agar plates or columbia blood agar respectively, with the sample concentration of 10 μg/mL. The plate of E. coli was incubated for 24 h at 37 °C and F. nuceatum was incubated in Shanghai CIMO YQX-11anaerobic chamber under an atmosphere of 85 % nitrogen, 10 % hydrogen and 5 % carbon dioxide. The numbers of colonies were counted after 24 h of incubation. The counts from three independent experiments corresponding to a particular sample were averaged.
The growth inhibition curve method was determined by serial doubling diluted the dispersion of the samples (20 μL) and incorporated into the wells of 96-well microtiter plate with 160 μL BHI broth. The 20 μL of the bacteria suspension (5 × 105 CFU/ml) was added to each well. For the oral bacteria, the mineral oil was added to the wells of 96-well plate and covered the plate with plastic film to keep a microaerophilic environment. The optical density (OD) value at 660 nm was recorded by the RT-2100C Microplate Reader machine at every 30 min intervals at 37 °C for 12 h. The minimum inhibitory concentration (MIC) value was recorded as the lowest concentration of the sample inhibiting the visible growth of microorganisms. A blank control without the sample was used for the control.
3 Results and discussion
3.1 Size and morphology of prepared Ag Nps samples
The purity and crystalline of the as-synthesized product was examined by powder XRD analysis. Fig. 1 showed the typical XRD pattern of the as-synthesized sample 3. The presence of the four diffraction peaks corresponding to 2θ values of (111), (200), (220), and (311) agrees with the values of elemental Ag (JCPS no. 04-0783). No other diffraction peaks were detected, indicating of the high purity of Ag. (The energy-dispersive X-ray microanalysis of sample 1 and sample 2 were shown in supporting information.)
Figure 2 shows the TEM images and histogram illustrating the morphology and size distribution of the three prepared Ag NPs. As shown in Fig. 2a, it can be seen that sample 1 presents well dispersed and spherical shape. Most of particle size varies from 3 to 8 nm and peak centered is about 5 nm. Sample 2 also presents well dispersed and spherical shape, the peak centered is at 15 nm and size range is from 7 to 25 nm. The size of sample 3 prepared by the hydrothermal method and PEG reduction is much larger than that of sample 1 and sample 2 which synthesized through the simple reduction method by NaBH4. The size distribution peak centered is at 55 nm with width from 30 to 80 nm. The morphology of the obtained Ag Nps does not change significantly with size, so the differences in the antibacterial results can only be attributed to the differences in size.
The UV–vis absorption spectra of the samples were presented in Fig. 3. All the samples present the characteristic surface plasmon of Ag Nps, sample 1 presents a narrow band with a maximum at 399 nm, sample 2 also has a narrow band, which presents a maximum at 404 nm, and sample 3 has a wider band, which presents a maximum at 436 nm. It is reported that the absorption spectrum of spherical Ag Nps presents a maximum between 420 and 450 nm with a blue or red shift when particle size diminishes or increases, respectively [20, 22]. For this reason, the maximum of 5 nm Nps presents a blue shift and 55 nm Nps presents a red shift with respect to that of 15 nm Ag. In the meantime, the absorption spectra of synthesized Ag Nps after keeping at room temperature for 3 months also showed in Fig. 3. It could be seen that the spectra of three sizes of Ag Nps after 3-month storage have no significant changes, which suggests that the produced Nps have high stability. The stability of Ag Nps is important for the antibacterial usage.
3.2 Antibacterial activity
The antibacterial activity of the as-synthesized Ag Nps of different size assessed by colony counting assay was shown in Fig. 4. From the figure we can see that the 5-nm Ag present the best antibacterial activity against E. coli and F. nuceatum. Aerobic bacteria E. coli was more susceptible to the tested Ag Nps than anaerobic bacteria F. nuceatum.
The time related effect of OD values of different size Ag Nps against the growth of anaerobic oral pathogenic bacteria S. mutans, S. sanguis, S. mitis, A. actinomycetemcomitans, F. nuceatum and aerobic E. coli are depicted in Fig. 5, and their corresponding MIC values are summarized in Table 1. As shown in Fig. 5, all three kind Ag Nps significantly inhibited the growth of five oral anaerobic pathogenic bacteria and aerobic E. coli, and increasing concentration of Nps progressively inhibited the growth of the bacteria. More importantly, the particles of different size showed different rate and extent of growth inhibition. For example, the 5-nm Ag can completely inhibit the growth of F. nuceatum at concentration of 25 μg/mL, for 15- and 55-nm Ag, the concentration is at 50 and 100 μg/mL, respectively. For A. actinomycetemcomitans, the corresponding MIC values of 5-, 15- and 55-nm Ag are 25, 50 and 200 μg/mL, respectively. The 5-nm Ag presented the best antibacterial activity towards all tested bacteria in this study, which is in agreement with the result of above colony count assay. The MIC value of 5-nm Ag against aerobic bacteria E. coli is 6 μg/mL, which lower than that of the five anaerobic bacteria, suggesting that the aerobic bacteria was more susceptible to Ag Nps than the anaerobic bacteria.
Though the exact mechanism of action of Ag Nps on microbes is still unknown, the possible mechanism involves the Nps get attached to the cell membrane and make a break through the permeability of the outer membrane [28, 29]. Then Ag Nps enter the inner membrane and inactivate respiratoty chain dehydrogenases [19, 30]. The size of the nanoparticle implies its surface area to come in contact with the bacterial cell. The smaller of the size of Ag NPs, the larger of surface area to come in contact with the bacteria, then the higher percentage of interaction with bacteria. So the bactericidal effect of Ag Nps is size dependent. Because of smallest size, 5-nm Nps present the greatest surface area in three samples; therefore the contact with bacteria is largest. This could be the reason that 5-nm Ag particles present the best antibacterial activity.
It was found that the antibacterial effect of Ag NPs obtained against five anaerobic oral pathogenic bacteria were lower than that against aerobic E. coli, and the possible explanation could be that: Ag NPs usually can be oxidized in aqueous solutions when exposed to air (Eq. 1), which resulting in the release of silver ions (Ag+) under acidic conditions (Eq. 2) [31]
According to recent report [32, 33], the mechanism that Ag NPs exert toxicity to bacteria depends strongly on Ag+ release, and Ag+ is the definitive molecular toxicant. Antibacterial activity could be controlled by modulating Ag+ release, possibly through manipulation of oxygen availability, particle size. As for aerobic E. coli, Ag+ can fully release from Ag NPs under sufficient air supply. For the anaerobic bacteria, the release of Ag+ is inhibited by insufficient air. The difference in release rate of Ag+ makes the difference in antibacterial effect for aerobic or anaerobic bacteria.
4 Conclusions
In this study, stable Ag Nps with different sizes (5, 15 and 55 nm) were prepared and characterized. The as-synthesized Ag NPs present apparent antibacterial activity against five anaerobic oral pathogenic bacteria S. mutans, S. sanguis, S. mitis, A. actinomycetemcomitans, F. nuceatum and aerobic bacteria E. coli. The antibacterial effect against anaerobic bacteria was lower than that of aerobic bacteria. Different size of Ag NPs also displayed different antibacterial activity against anaerobic oral pathogenic bacteria. 5-nm Ag NPs present the best antibacterial activity. Considering higher antimicrobial properties and less toxicity of Ag NPs than Ag compounds, such as silver nitrate [34] and silver sulfadiazine [35], which could be used for the treatment of periodontal pathogens, there has been the potential use of Ag NPs to prevent or control dental caries and periodontal disease. Ag NPs can be applied as oral antibacterial materials in the form of dental restorative material, end-odontic retrofill cement, dental implants, caries inhibitory solution and mouthwash. However, further investigations are necessary for a better understanding the influence of Ag NPs on the oral normal bacterial flora and the cytotoxicity of Ag NPs towards oral cells before proposing their therapeutic use.
References
Gaengler P, Markovic L, Norden D, et al. New insights in understanding dental caries and periodontal disease: the avalanche model. Health. 2009;1:263–8.
Bagramian RA, Garcia-Godoy F, Volpe AR. The global increase in dental caries. A pending public health crisis. Am J Dent. 2009;22:3–8.
Qi XQ. 3th survey of oral health status of population in China. Beijing: People’s Medical Publishing House; 2008.
Marsh P, Martin MV, Lewis MAO. Oral microbiology. London: Churchill Livingstone; 2009.
Kolenbrander PE, Palmer RJ, Periasamy S, et al. Oral multispecies biofilm development and the key role of cell–cell distance. Nat Rev Microbiol. 2010;8:471–80.
Selwitz RH, Ismail AI, Pitts NB. Dental caries. Lancet. 2007;369:51–9.
Love R, Jenkinson H. Invasion of dentinal tubules by oral bacteria. Crit Rev Oral Biol Med. 2002;13:171–83.
Loesche WJ. Role of Streptococcus mutans in human dental decay. Microbiol Res. 1986;50:353.
Zambon JJ. Actinobacillus actinomycetemcomitans in human periodontal disease. J Clin Periodontol. 1985;12:1–20.
Kinder SA, Holt SC. Localization of the Fusobacterium nucleatum T18 adhesin activity mediating coaggregation with Porphyromonas gingivalis T22. J Bacteriol. 1993;175:840–50.
Leistevuo J, Järvinen H, Sterblad M, et al. Resistance to mercury and antimicrobial agents in Streptococcus mutans isolates from human subjects in relation to exposure to dental amalgam fillings. Antimicrob Agents Chemother. 2000;44:456.
Espinosa-Cristóbal LF, Martínez-Castañón GA, Martínez-Martínez RE, et al. Antibacterial effect of silver nanoparticles against Streptococcus mutans. Mater Lett. 2009;63:2603–6.
Altman H, Steinberg D, Porat Y, et al. In vitro assessment of antimicrobial peptides as potential agents against several oral bacteria. J Antimicrob Chemother. 2006;58:198.
Rai MK, Deshmukh SD, Ingle AP, et al. Silver nanoparticles: the powerful nanoweapon against multidrug-resistant bacteria. J Appl Microbiol. 2012;112:841–52.
Kim JS, Kuk E, Yu KN, et al. Antimicrobial effects of silver nanoparticles. Nanomedicine. 2007;3:95–101.
Sondi I, Salopek-Sondi B. Silver nanoparticles as antimicrobial agent: a case study on E. coli as a model for Gram-negative bacteria. J Colloid Interface Sci. 2004;275:177–82.
Shahverdi AR, Fakhimi A, Shahverdi HR, et al. Synthesis and effect of silver nanoparticles on the antibacterial activity of different antibiotics against Staphylococcus aureus and Escherichia coli. Nanomedicine. 2007;3:168–71.
Jun BH, Byun JW, Kim JY, et al. Facile method of preparing silver-embedded polymer beads and their antibacterial effect. J Mater Sci. 2010;45:3106–8.
Rai M, Yadav A, Gade A. Silver nanoparticles as a new generation of antimicrobials. Biotechnol Adv. 2009;27:76–83.
Pal S, Tak YK, Song JM. Does the antibacterial activity of silver nanoparticles depend on the shape of the nanoparticle? A study of the gram-negative bacterium Escherichia coli. Appl Environ Microbiol. 2007;73:1712–20.
Yoon KY, Hoon Byeon J, Park JH, et al. Susceptibility constants of Escherichia coli and Bacillus subtilis to silver and copper nanoparticles. Sci Total Environ. 2007;373:572–5.
Martinez-Castanon GA, Nino-Martinez N, Martinez-Gutierrez F, et al. Synthesis and antibacterial activity of silver nanoparticles with different sizes. J Nanopart Res. 2008;10:1343–8.
Cao XL, Cheng C, Ma YL, et al. Preparation of silver nanoparticles with antimicrobial activities and the researches of their biocompatibilities. J Mater Sci Mater Med. 2010;21:2861–8.
Marius S, Lucian H, Marius M, et al. Enhanced antibacterial effect of silver nanoparticles obtained by electrochemical synthesis in poly(amide-hydroxyurethane) media. J Mater Sci Mater Med. 2011;22:789–96.
Hernández-Sierra JF, Ruiz F, Pena DC, et al. The antimicrobial sensitivity of Streptococcus mutans to nanoparticles of silver, zinc oxide, and gold. Nanomedicine. 2008;4:237–40.
Slenters TV, Hauser-Gerspach I, Daniels AU, et al. Silver coordination compounds as light-stable, nano-structured and anti-bacterial coatings for dental implant and restorative materials. J Mater Chem. 2008;18:5359–62.
Sadeghi R, Owlia P, Taleghani F, et al. An in vitro comparison between antimicrobial activity of nanosilver and chlorhexidine against Streptococus sanguis and Actinomyces viscosus. J Islamic Dent Assoc Iran. 2011;23:225–31.
Shrivastava S, Bera T, Roy A, et al. Characterization of enhanced antibacterial effects of novel silver nanoparticles. Nanotechnology. 2007;18:225103.
Li WR, Xie XB, Shi QS, et al. Antibacterial activity and mechanism of silver nanoparticles on Escherichia coli. Appl Microbiol Biotechnol. 2010;85:1115–22.
Lok CN, Ho CM, Chen R, et al. Proteomic analysis of the mode of antibacterial action of silver nanoparticles. J Proteome Res. 2006;5:916–24.
Liu J, Hurt RH. Ion release kinetics and particle persistence in aqueous nano-silver colloids. Environ Sci Technol. 2010;44:2169–75.
Sotiriou GA, Pratsinis SE. Antibacterial activity of nanosilver ions and particles. Environ Sci Technol. 2010;44:5649–54.
Xiu ZM, Zhang QB, Puppala HL, et al. Negligible particle-specific antibacterial activity of silver nanoparticles. Nano Lett. 2012;12:4271–5.
Spacciapoli P, Buxton D, Rothstein D, et al. Antimicrobial activity of silver nitrate against periodontal pathogens. J Periodontal Res. 2002;36:108–13.
Brandt O, Mildner M, Egger AE, et al. Nanoscalic silver possesses broad-spectrum antimicrobial activities and exhibits fewer toxicological side effects than silver sulfadiazine. Nanomedicine. 2012;8:478–88.
Acknowledgments
This work was supported by the Program for New Century Excellent Talents in University (NCET-09-0136), the Key Program of Hubei Provincial Department of Education (D20111510), the Outstanding Youth Science Foundation of Hubei Province (2009CDA075), Natural Science Foundation of Hubei Province (2011CDB219) and the International Cooperation Program of Hubei Province (2011BFA021).
Author information
Authors and Affiliations
Corresponding author
Electronic supplementary material
Below is the link to the electronic supplementary material.
Rights and permissions
About this article
Cite this article
Lu, Z., Rong, K., Li, J. et al. Size-dependent antibacterial activities of silver nanoparticles against oral anaerobic pathogenic bacteria. J Mater Sci: Mater Med 24, 1465–1471 (2013). https://doi.org/10.1007/s10856-013-4894-5
Received:
Accepted:
Published:
Issue Date:
DOI: https://doi.org/10.1007/s10856-013-4894-5